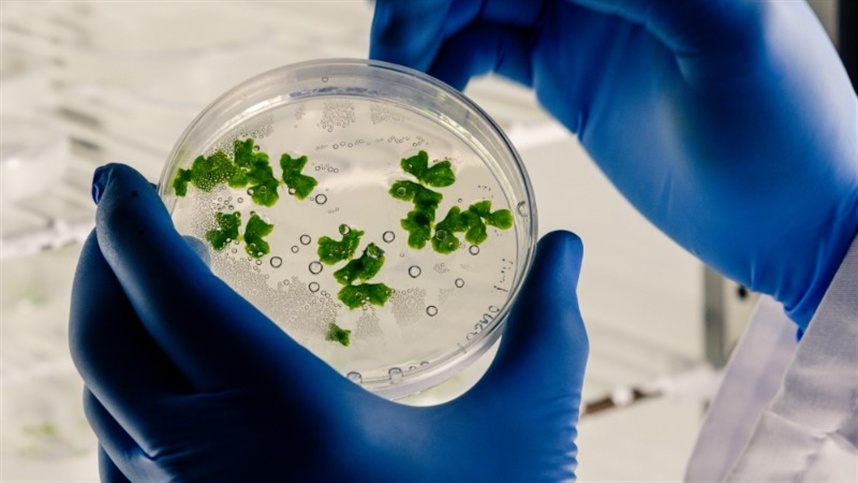

Inovações biotecnológicas e edição gênica via CRISPR
Ferramentas da biotecnologia têm um papel fundamental na agricultura moderna
As ferramentas da biotecnologia têm um papel fundamental na agricultura moderna, especialmente no desenvolvimento e aprimoramento de sementes. No XXII Congresso Brasileiro de Sementes (CBSementes), um dos maiores eventos brasileiros do setor, a Dra. Liliane Mertz Henning, pesquisadora da Embrapa Soja, será uma das palestrantes com o tema “Biotecnologia na área da edição gênica”.
Durante sua palestra, Liliane vai destacar as mais recentes inovações biotecnológicas, com foco especial na edição gênica via CRISPR. "Vamos explicar o conceito, o histórico da descoberta dessa ferramenta revolucionária e como ela está sendo aplicada, tanto no Brasil quanto globalmente", antecipa a pesquisadora. Através da edição genômica, técnicas como a CRISPR permitem modificações precisas no DNA das plantas, resultando em culturas com maior resistência a doenças, pragas e condições climáticas adversas.
Além disso, a palestra abordará outro avanço importante: a RNA de interferência de uso tópico, uma tecnologia descoberta no final dos anos 1990, e que recentemente foi disponibilizada comercialmente para uso na agricultura. “No ano passado tivemos um marco importante, foi lançado nos Estados Unidos um inseticida à base dessa técnica, destinado ao controle de pragas agrícolas”, enfatiza.
Liliane Henning também pretende abordar os desafios regulatórios que acompanham essas tecnologias. "É essencial que o avanço tecnológico seja acompanhado por um marco regulatório robusto, tanto no Brasil quanto no cenário internacional", conclui a pesquisadora.
CBSementes – Promovido pela Associação Brasileira de Tecnologia de Sementes, a XXII edição do CBSementes vai acontecer de 10 a 13 de setembro de 2024, no Rafain Palace Hotel, em Foz do Iguaçu (PR), com o tema "Semente: A Matéria-prima da Sustentabilidade".
O evento é voltado para pesquisadores, agrônomos, produtores rurais, acadêmicos, representantes de empresas do setor agrícola, formuladores de políticas públicas e interessados na temática da sustentabilidade e inovação no setor de sementes.
O CBSementes vai contar com palestras, mesas-redondas, debates e exposições sobre temas como qualidade, sanidade, inovação, legislação e políticas públicas para o setor, além de espaço para expositores, showroom e submissão de trabalhos. Para se inscrever acesse aqui.
Serviço
Evento: XXII Congresso Brasileiro de Sementes (CBSementes)
Data: 10 a 13 de setembro de 2024
Local: Rafain Palace Hotel & Convention em Foz do Iguaçu (PR).
Inscrições: https://cbsementes.com/